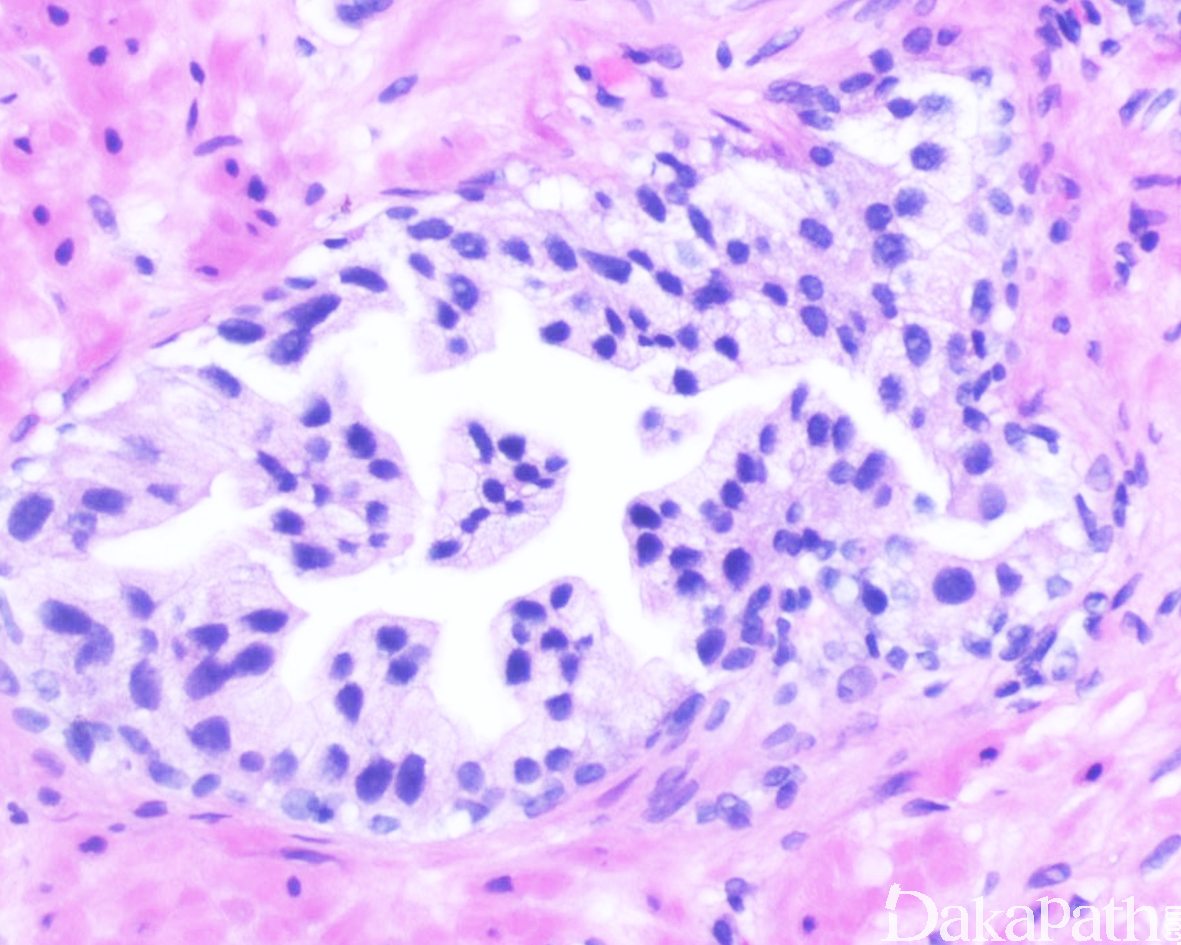

高级别前列腺上皮内瘤变
High Grade Prostatic Intraepithelial Neoplasia
同义词(或曾用名): 前列腺上皮内瘤变 II 级及 III 级
概述:
浸润性前列腺腺癌的癌前病变,表现为前列腺导管内或腺泡分泌细胞的恶性病变,瘤细胞具有间变性核和明显核核仁,而基底细胞尚保存。
发病部位: 前列腺
诊断要点:
其发病率随年龄增长而上升,不同人种发病率相差较大,常呈多灶性;穿刺活检的发病率约 5%;
最常见于前列腺外周带,全组织包埋切片显示> 85%以上的 HGPIN 与浸润性癌共存;
组织学表现为前列腺导管和腺泡分泌上皮的增生,组织结构主要有四种:簇状、微乳头状、筛状及平坦型;通常为多灶性,同一肿瘤内可有多种组织学类型;
上皮细胞呈圆形或卵圆形,核特征类似于腺癌,包括核增大、核仁突出;其它细胞学特点包括胞浆空泡状、印戒样细胞、小细胞、鞋钉样细胞、内翻性、鳞状上皮分化、黏液样、泡沫状等;
基底层细胞常呈节段性分布或部分丢失,基底层细胞丢失区域腺体局灶向外突出,提示早期间质浸润的可能,但也可能是大而不规则的腺体或分支的斜向切面。

免疫组织化学染色:
基底细胞标记 P63. P40、34βE12 节段性丢失,CK5/6 可阴性,AMACR 常阳性,ERG 阳性比例与浸润性癌相似。
分子标记:
8p12-21 和 8p22 等杂合性缺失;7,8,10,12 以及 8p24 等染色体获得;ERG 蛋白过表达和 PTEN 表达丢失
鉴别诊断:
HGPIN 样腺癌:可见于普通的腺泡细胞腺癌共存,过渡或移行,免疫组化染色基底细胞完全丢失;
前列腺导管内癌:瘤细胞结构更复杂,致密的筛状或实性结构,伴或不伴有粉刺样坏死,瘤细胞异型性更明显,疏松的筛状结构内瘤细胞的多形性常超过 6 倍以上。
前列腺导管腺癌:瘤细胞呈假复层柱状排列,常见带有纤维血管轴心的分支乳头状结构,组织学类似于子宫内膜样腺癌,免疫组化染色大多数基底细胞表达丢失,偶尔可保留类似于导管内生长。
预后:
穿刺活检标本中的孤立性 HGPIN 重复活检后癌的发生率约 20-25%
治疗:
穿刺活检标本中的孤立性 HGPIN(仅累及一个穿刺组织条)在无其他临床表现的情况下,在 1 年内无需再次重复活检;而在穿刺活检中的多灶性 HGPIN(累及多个组织条),则推荐在 1 年内进行重复的穿刺活检
病例报道:
[Mutation Profiling IndicatesHigh Grade Prostatic Intraepithelial Neoplasiaas Distant Precursors of Adjacent Invasive Prostatic Adenocarcinoma.](http://onlinelibrary.wiley.com/doi/10.1002/pros.23212/abstract;jsessionid=BAED5185BDC95F6311E076A8191BC9C6. f01t01?systemMessage=Wiley+Online+Library+will+be+unavailable+on+Saturday+3rd+September+2016+at+08.30+BST%2F+03%3A30+EDT%2F+15%3A30+SGT+for+5+hours+and+Sunday+4th+September+at+10%3A00+BST%2F+05%3A00+EST%2F+17%3A00+SGT+for+1+hour++for+essential+maintenance.+Apologies+for+the+inconvenience)
参考文献:
Zhou M. High-grade prostatic intraepithelial neoplasia, PIN-like carcinoma, ductal carcinoma, and intraductal carcinoma of the prostate. Modern Pathology (2018) 31, S71–S79
